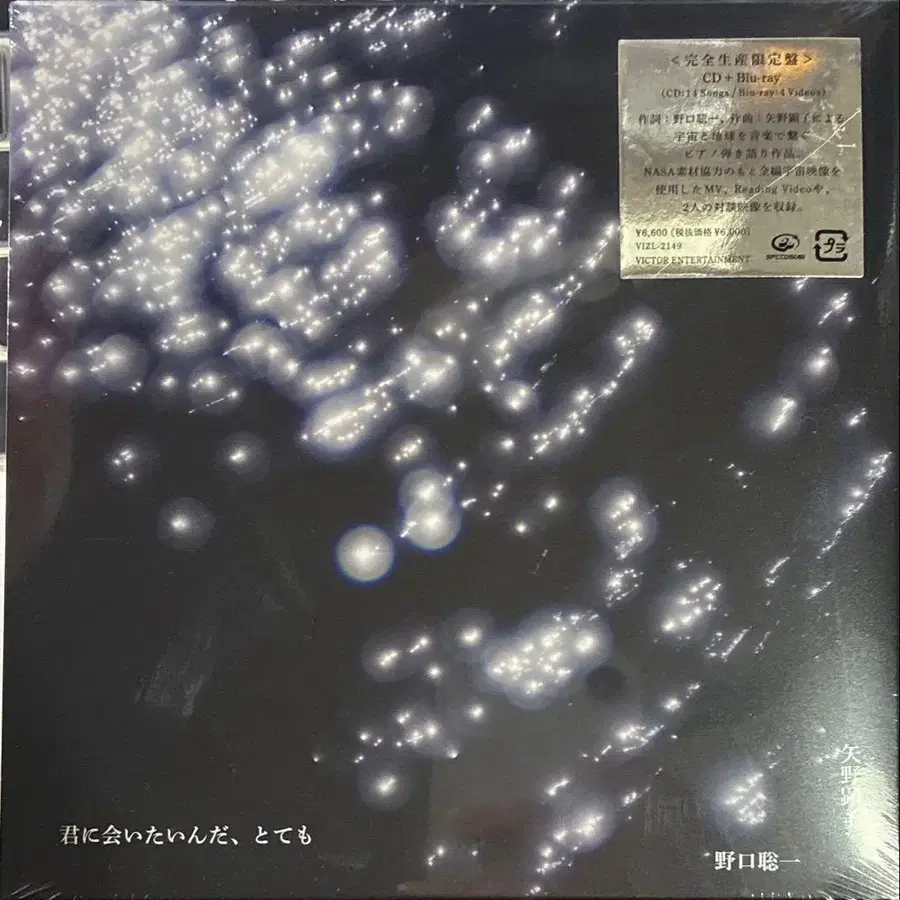
1번째 상품 이미지

일본에서 배송되는 상품이에요
미개봉) 야노 아키코/노구치 소이치 너를 만나고 싶어, 정말 CD+BD
77,938원
5%74,041원
해외 배송비,관부가세가 모두 포함된 가격도쿄・18시간 전
0
메루카리(mercari)
결제혜택
더보기
퀵계좌이체 결제 시 0.3% 즉시 할인
컬쳐캐쉬 결제 시 최대 5천원 페이백
현대카드 최대 24개월 장기할부 혜택 제공
롯데카드 최대 24개월 장기할부 혜택 제공
하나카드 최대 18개월 장기할부 혜택 제공
국민카드 12개월 장기할부 혜택 제공
계좌 간편결제 시 번개포인트 1% 적립
무이자할부/카드포인트 결제 혜택 제공